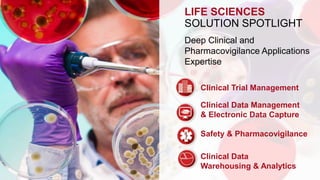
LIFE SCIENCES 
SOLUTION SPOTLIGHT 
Deep Clinical and 
Pharmacovigilance Applications 
Expertise 
Clinical Trial Management 
Clinical Data Management 
& Electronic Data Capture 
Safety & Pharmacovigilance 
Clinical Data 
Warehousing & Analytics

Perficient is a national Oracle partner and systems integrator with over 1,800 customer implementations across various Oracle solutions and industries. It has extensive expertise in Oracle cloud, E-Business Suite, Hyperion, CX, BI, and technology solutions. Perficient also uses Oracle within its own business. It has a track record of successful customer engagements and transformations across industries like healthcare, life sciences, financial services, consumer markets, and energy.